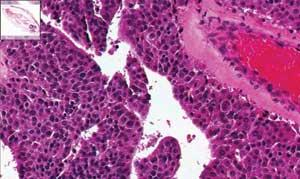
Th Largest 1109 01

“The largest pathology image ever” produced depicts a breast tissue sample. It is available at the website of Biomedical Photometrics Inc. (BPI; Waterloo, ON Canada), where a Google Earth-like interface allows you to zoom in and out, and wander around the specimen. BPI’s website displays a number of brightfield and confocal fluorescence pathology images generated by its TISSUEscope 4000 slide scanner (www.confocal.com/RESOURCES/ImageGallery.html).
The instrument accommodates specimens up to 5 x 7 inches; it is based on patented, proprietary confocal submicron laser scanning technology, which enables panoramic, fluorescence and brightfield imaging in minutes. The technology replaces conventional microscope objectives with telecentric f*theta laser scan lenses and new scanning optics, which enables a viewing area more than 100 times that of a conventional microscope with the same resolution. The incoming laser beam is focused to a spot on the microscope and this spot is moved across the width of the slide by a scanning mirror. Simultaneously, the slide is moved along its length, resulting in a raster scan of the focused laser spot across the surface of the slide. Reflected or fluorescent light from the specimen is collected by the scan lens and detected using a photomultiplier tube. Data are collected one pixel at a time during the scan and assembled into a digital image file (three channels can be detected simultaneously).
Laser treatment = no sweat
Hyperhidrosis, or chronic, excessive sweating, affects millions of people–approximately three percent of the population according to the Cleveland Clinic (Ohio). Now an hour-long procedure called laser sweat ablation (LSA) offers new hope to sufferers, who in some cases have gone to extreme and dangerous measures to address the problem. The approach, pioneered by Argentinian plastic surgeon Guillermo Blugerman, is described in a chapter (“Laser-Assisted Suction of Axillary Sweat Glands and Axillary Epilation”) of the book Liposuction Principles and Practice (Springer Berlin Heidelberg).
This year the procedure became available in the UK, thanks to Whitely Clinic (Guildford, UK) consultant surgeon Mark Whitely, who maintains the Laser Sweat Ablation Blog at http://lasersweatablation.blogspot.com. Whitely says the procedure uses a Fontona XP2 laser. “It is an Nd:YAG crystal,” he explains, “a 1064 nm wavelength quasi-continuous wave laser that actually pulses at 40 Hz.”
As described in the Sydney Morning Herald (Australia), the armpit is first coated with iodine and a starch is applied to locate the glands. The patient is given a local anesthetic before a 3mm incision is made. The laser then burns away the gland. The procedure allows patients to resume normal activities the same day.
Whitley will present results on the procedure during the Instumentation, Measurement, Circuits and Systems (IMCAS) meeting in January 2010 in Paris, France.
Facial hair removal gaining
According to Cosmetic Physicians Society of Australasia (CPSA), men are increasingly seeking the permanent removal by laser of hair from their face and neck. The trend is part of a growing acceptance by men of cosmetic hair removal in general, said CPSA president Mary Dingley, A poll of CPSA members shows that facial hair follows removal of back and chest hair in terms of popularity.
About the Author

Barbara Gefvert
Editor-in-Chief, BioOptics World (2008-2020)
Barbara G. Gefvert has been a science and technology editor and writer since 1987, and served as editor in chief on multiple publications, including Sensors magazine for nearly a decade.